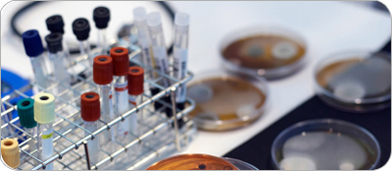
pharm

Industries
Aggregate

The Branham Corporation offers a wide array of products and services to meet the rugged applications of the aggregate industry. We provide industrial hose, couplings and accessories for water suction and discharge applications, air, hydraulic and bulk material handling.
Our comprehensive line of conveyor products provide economical, durable and proven solutions for all your conveyor needs. We provide and install impact cradles and belt support systems for use on your primary and secondary crushers as well as belt cleaners, wear liners, skirt board, tail pulley protection, idlers and conveyor belt.
Our field service crews can change out and splice your conveyor belt (both mechanical and vulcanized) with minimal down time.
Branham Corporation can also provide economical and high-quality power transmission products through our IDC Group. Contact us for all of your chain, sprockets, bearings, drive belts and gear motor needs.
Automotive Manufacturing

The automotive industries have a wide range of applications from metal stamping or high pressure SS/Teflon hoses for bumper molding, to people mover belts. Branham Corporation has products which offer excellent reliability and low maintenance because they meet the highest quality standards.We provide30+ years of experience in servicing the automotive manufacturing and component supplier industries, giving Branham Corporation a wide range of products in the automotive industries.
Chemical Transportation

Branham Corporation offers several select product lines to meet the rugged demands and exceed the standards of the chemical transportation industry. Our fluid transfer hose, fittings, gasketing and the latest in safety products are all designed and manufactured for optimum durability, chemical compatibility, and driver safety.
Construction

Branham Corporation provides superior products for service in the construction industry. Our industrial hose & fittings for applications such as compressed air & jack hammer hose, suction/discharge, water, steam and hydraulic hose assemblies are just a few of the many products Branham carries. Branham also offers custom fabrication for your specific application.
Food Industry

Industrial food processing requires a wide range of products to meet the demands of round-the-clock production plus close inspection by such regulatory agencies as the FDA, USDA, and other industry specific groups.
Branham Corporation represents select manufacturers, allowing our customers the opportunity to choose the best product for their application. In addition to food belting Branham Corporation offers many styles of food grade hose for direct product transfer of liquids and dry bulk materials.
Mining

In Mining our products and services meet the industry’s high standard for design, service and reliability. Our hydraulic hose and couplings keep your equipment operating safely and efficiently while our Staple Lok fittings allow for quick and easy hose connections. Our MSHA approved mine spray/wash down hoses provide proven economical service.
We offer rugged mine duty Belt Support and Belt Cleaning Systems to reduce material spillage and carry-back to keep your material flowing. We can also supply, install and splice any of your conveyor belt needs.
Paper, Pulp, and Packaging

In Mining our products and services meet the industry’s high standard for design, service and reliability. Our hydraulic hose and couplings keep your equipment operating safely and efficiently while our Staple Lok fittings allow for quick and easy hose connections. Our MSHA approved mine spray/wash down hoses provide proven economical service.
We offer rugged mine duty Belt Support and Belt Cleaning Systems to reduce material spillage and carry-back to keep your material flowing. We can also supply, install and splice any of your conveyor belt needs.
Petrochemical & Chemical Processing

Branham Corporation offers a complete range of products that provide superior performance in the safe transfer and sealing of media in the chemical processing industry.
We provide a comprehensive line of metal hoses in metallurgies that include carbon steel, stainless steel, Monel™, Hastelloy®, Teflon®-lined hoses and specialty hoses for chlorine service to meet all of your critical service applications. All of our hoses are tested, tagged, identified and tracked within the Branham Corporation database and we provide in-plant hose and fitting safety audits.
We offer complete fluid and gas sealing product recommendations for all of your gasket applications including heat exchangers, glass-lined equipment, towers/reactors and non-metallic flanges. We can also assist with the proper selection of compression packing and expansion joints for all of your critical applications.
Pharmaceutical
Branham Corporation offers products for the pharmaceutical Industry that exceed industry standards. Our select manufacturers of hose, gaskets sealants supply products for optimum durability in sanitary applications.
Branham Corporation fabricates hose assemblies with end fittings such as Flare Through TFE, encapsulated fittings and several styles of sanitary connections which allow transfer of your product while reducing the potential for contamination.
Power Generation

Branham Corporation offers products for the pharmaceutical Industry that exceed industry standards. Our select manufacturers of hose, gaskets sealants supply products for optimum durability in sanitary applications.
Branham Corporation fabricates hose assemblies with end fittings such as Flare Through TFE, encapsulated fittings and several styles of sanitary connections which allow transfer of your product while reducing the potential for contamination.
Refining

Branham Corporation offers a wide range of products for the Refining Industry. Branham Corporation represents manufacturers with Engineered Products for critical gas and fluid handling applications which offer superior reliability and high performance service.
Steel Processing

Branham Corporation provides the most comprehensive line of industrial hose and fitting products available to the steel industry today. Our specialty fabricated roof cooling hoses, stainless steel hose assemblies, hydraulic hose and fittings and special quick disconnect fittings provide superior service for the demanding needs of the steel processing industry.
We provide in-plant hose and fitting safety audits and all hose and fitting products are assembled in each Branham Corporation facility by certified technicians. Our hose assemblies can be identified and tracked within the Branham Corporation database.
In addition to our industrial hose products we also offer custom-fabricated gaskets, expansion joints and sealing products that often exceed the OEM products at a more economical price.
We also feature a complete urethane and rubber roll covering operation where we can re-cover your existing rollers or else provide new rollers, depending upon your needs.
